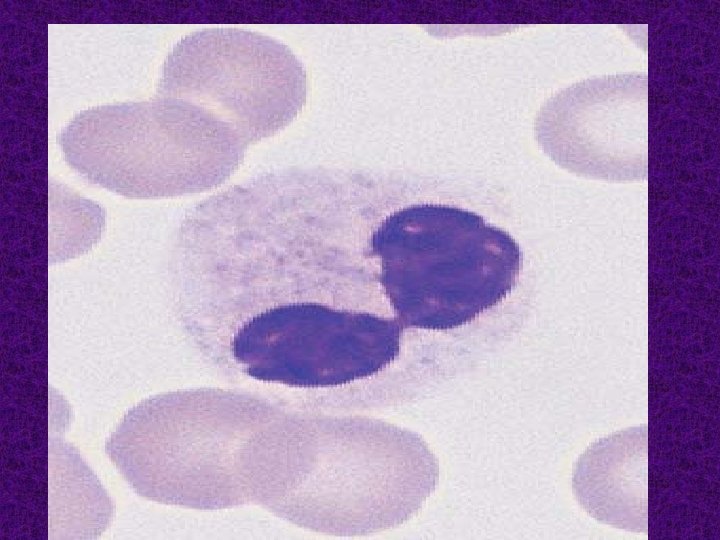
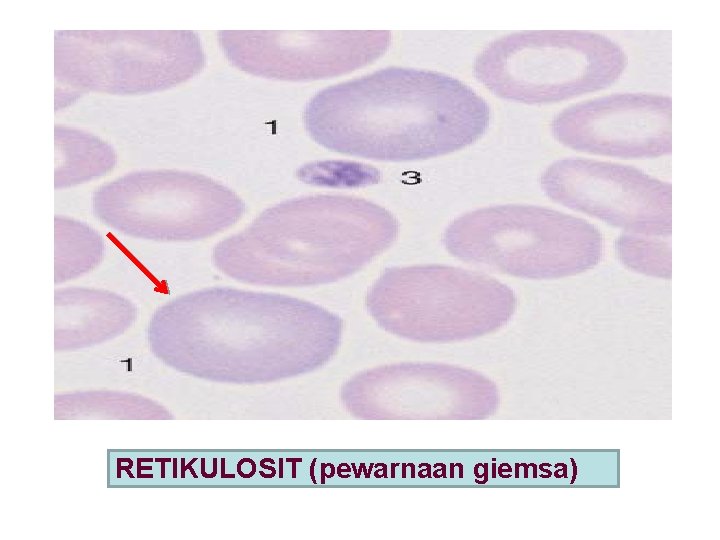
RETIKULOSIT (pewarnaan giemsa)

PEMERIKSAAN LABORATORIUM PADA ANEMIA APLASTIK ELLYZA NASRUL MENURUT

PEMERIKSAAN LABORATORIUM PADA ANEMIA APLASTIK ELLYZA NASRUL

MENURUT WINTROBE (1959): Anemia aplastik: - Merupakan kasus pansitopenia, hipoplasia berat atau aplasia sumsum tulang, tanpa ada suatu penyakit primer yg menginfiltrasi, mengganti atau menekan jaringan hemopoetik sumsum tulang.

ANEMIA APLASTIK ADALAH: - Suatu gangguan yg ditandai de- ngan: * Hilangnya sel hemopoetik * Penggantian sumsum tulang dgn jaringan lemak * Terdapatnya pansitopenia

KLASIFIKASI ANEMIA BERDASARKAN MORFOLOGI 1. A. mikrositik hipokrom: - Defisiensi Fe - Talasemia 2. Makrositik: - Def. B 12, Folat - Peny. Hati 3. Normositik normokrom: - A. aplastik - A. hemolitik - Perdarahan - dll

LABORATORIUM I. Darah tepi 1. Hemoglobin (Hb) - Menurun (anemia) 2. Sel darah - Pd std awal pansitopenia tdk selalu ditemukan - Jenis anemia: normositik normokrom

- Kadang-kadang ditemukan pula: makrositosis, anisositosis dan poikilositosis - Granulosit dan trombosit ditemukan rendah - Limfositosis relatif >75% kasus. - Retikulosit: normal atau rendah. Adanya retikulositosis bukan A. aplastik

3. Laju endap darah - Selalu meningkat - Mempunyai laju endap darah lebih dari 100 mm dalam jam pertama 89%

II. Faal Hemostasis 1. Waktu perdarahan memanjang 2. Retraksi bekuan buruk tidak kenyal dan rapuh. disebabkan oleh trombositopenia 3. Faal hemostasis lainnya normal

III. Sumsum tulang - Aspirasi sumsum tulang sering tdk berhasil (dry tap) - Bila berhasil sedikit partikel, dgn sel lemak yg banyak , sel limfosit merata dan jarang. - Sel granulosit sedikit

- Megakariosit sering tidak dite mui - Seri eritropoetik menurun jumlahnya, berbagai tipe sel ini dapat ditemui, mungkin memperlihatkan gambaran yg megaloblastik

DIAGNOSIS 1. PANSITOPENIA - Pria Hb: < 13 g/dl Wanita < 12 g/dl - Jumlah leukosit < 4000/mm 3 - Jumlah trombosit < 150. 000/mm 3 2. Aplasia atau hipoplasia sumsum tlg - Peningkatan sel lemak - Hipoplasia seri eritroid, mieloid dan megakariosit, limfosit relatif meningkat *** Adanya hipoplasia berat dan peningkatan sel lemak kriteria diagnosis

HEMOPOETIK • • • 1. ERITROPOETIK 2. MIELOPOETIK 3. TROMBOPOETIK 4. LIMFOPOETIK 5. MONOPOETIK

RUBRIBLAS PLASMOBLAS LIMFOBLAS STEM CELL L I M MEGAKARIOBLAS MIELOBLAS MONOBLAS

SERI ERITROPOITIK

TROMBOSIT T R TROMBOPOETIK T R O M Sel megakariosit

Sumsum tulang normal

Sel retikulosit
RETIKULOSIT (pewarnaan giemsa)

Sum sum tulan g A. Aplastik


Sel retikulosit

Normositik normokrom

Anemia mikrositik hipokrom

GAMBARAN SSTL PADA ANEMIA APLASTIK

- Slides: 26